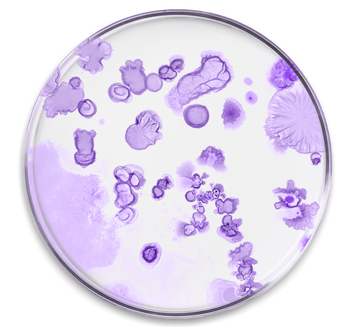

probaderm
probaderm
Aktuell sehr beliebt!
Intensive 5-in-1-Pflege mit Mikroorganismen für Ihre Haut: Spendet Feuchtigkeit, beruhigt, stärkt, gleicht aus und schützt.
- Speziell entwickelt für Psoriasis, Ekzeme und Neurodermitis
- Lindert Juckreiz, Brennen und Hautreizungen sofort
- Spendet langanhaltende Feuchtigkeit für ein angenehmes Hautgefühl
- Stärkt und repariert die Hautbarriere für widerstandsfähige Haut
- Unterstützt ein gesundes Hautmikrobiom mit probiotischem Extrakt
- Angereichert mit Jojoba-, Mandel- und Borretschöl sowie Sheabutter für intensive Pflege
- 50ml Tube
- Mikrobiotische IntensivcremeSpendet Feuchtigkeit, beruhigt, stärkt, gleicht aus und schützt Ihre Haut
- Mit Lactobacillus-ExtraktUnterstützt ein gesundes Hautmikrobiom
Mehr kaufen, mehr sparen!



Verfügbarkeit für Abholungen konnte nicht geladen werden

Bezahlen nach 30 Tagen mit Klarna.
-
Gratis Versand ab € 30
-
Lieferzeit 1-2 Werktage
-
90-Tage-Geld-zurück-Garantie







probaderm
-
Ohne Duftstoffe
-
Ohne synthetische Farbstoffe
-
Ohne Parabene
-
Ohne Parfüm
-
Tierversu- chsfrei
-
Ohne Gentechnik
Einklappbarer Inhalt
Inhaltsstoffe
Wasser, Jojobaöl (Simmondsia chinensis), Cetearylalkohol,
Glycerylstearatcitrat, Süßmandelöl (Prunus amygdalus dulcis), Glycerin, Lactobacillus-Extraktfiltrat, Borretschöl (Borago officinalis),
Sorbit, Sheabutter (Butyrospermum parkii), Benzylalkohol,
Saccharidisomerat, Propylenglykol, Natriumstearoylglutamat,
Xanthan, Benzoesäure, Tocopherol, Sorbinsäure, Milchsäure,
Zitronensäure, Natriumcitrat
Einnahmehinweis
Tragen Sie die Creme morgens und abends auf die betroffenen Hautstellen auf. Bei Bedarf können Sie Nupure Probaderm häufiger anwenden. Für optimale Ergebnisse verwenden Sie die Creme kontinuierlich.
Wichtige Hinweise
Die Creme kann von Kindern ab 3 Jahren und von Erwachsenen, insbesondere solchen mit geschwächter Hautschutzbarriere, angewendet werden.
Mikrobiotische Wissenschaft in jedem Tropfen
Probaderm kombiniert fortschrittliche mikrobiotische Forschung mit pflanzlichen Feuchtigkeitsspendern und bietet fünf essentielle Vorteile für gesündere und widerstandsfähigere Haut.

- 1 Spendet Feuchtigkeit: Glycerin und natürliche Öle versorgen die Haut mit Feuchtigkeit und beugen Austrocknung vor.
- 2 Beruhigt: Sanfte Wirkstoffe lindern Juckreiz, Brennen und Irritationen.
- 3 Stärkt: Stärkt die Hautbarriere und reduziert so Empfindlichkeit und Trockenheit.
- 4 Bringt die Haut ins Gleichgewicht: Lactobacillus-Extrakt unterstützt das natürliche Mikrobiom der Haut für ein langfristig harmonisches Hautbild.
- 5 Schützt: Bildet eine Schutzschicht, die vor äußeren Einflüssen und Feuchtigkeitsverlust schützt.
-
4pflegende Pflanzenöle für intensive Feuchtigkeitsversorgung
-
1Milchsäurebakterienstamm zur Unterstützung des Hautmikrobioms
-
100%frei von Duftstoffen, Parabenen und synthetischen Zusatzstoffen
So funktioniert Probaderm
- 1Bildet eine Schutzschicht und versorgt die Haut mit essentiellen Lipiden und Feuchtigkeit.
- 2Pflanzenöle und Feuchthaltemittel helfen, die Hautbarriere wiederherzustellen und den transepidermalen Wasserverlust zu reduzieren.

- 3Lactobacillus-Extrakt unterstützt das mikrobielle Gleichgewicht, indem er ein Hautmilieu schafft, das nützliche Bakterien begünstigt.
- 4Eine ausgeglichene Hautflora und eine gestärkte Hautbarriere tragen zur Linderung von Trockenheit, Rötungen und Irritationen bei.
Unsere sorgfältig ausgewählten Inhaltsstoffe

FAQ
-
Wie wird Probaderm angewendet?
Tragen Sie ein- bis zweimal täglich eine dünne Schicht der Creme auf die gereinigte, trockene Haut auf. Massieren Sie die Creme sanft in die betroffenen Stellen ein, bis sie vollständig eingezogen ist. Für optimale Ergebnisse regelmäßig anwenden.
-
Kann Probaderm im Gesicht angewendet werden?
Ja, Probaderm ist für die Anwendung im Gesicht und am Körper geeignet. Es ist frei von Duftstoffen und reizenden Inhaltsstoffen und wird auch von empfindlicher Gesichtshaut gut vertragen. Augenkontakt vermeiden.
-
Ist Probaderm für Kinder geeignet?
Ja, Probaderm kann von Kindern ab 3 Jahren angewendet werden. Die milde, parfümfreie Formel ist speziell für empfindliche und zu Irritationen neigende Haut entwickelt und dermatologisch getestet.
-
Kann Probaderm langfristig angewendet werden?
Ja, Probaderm ist für die kontinuierliche Anwendung konzipiert. Es kann als Teil der täglichen Hautpflege verwendet werden, um die Hautbarriere und das mikrobielle Gleichgewicht langfristig zu unterstützen.
-
Für welche Hauttypen oder Hautzustände wird Probaderm empfohlen?
Probaderm eignet sich ideal für trockene, empfindliche und reaktive Haut. Es ist auch als unterstützende Pflege bei Haut geeignet, die zu Neurodermitis (atopischer Dermatitis), Psoriasis, Akne, Rosacea und allgemeiner Irritation neigt.

Wie können wir Ihnen helfen?
-
E-Mail an info@nupureshop.com
-
Anruf unter +49 (0)8276 5187790
-
WhatsApp: +49 (0)8276 9099967
Bleiben Sie auf dem Laufenden
Exklusive Sonderangebote, Produkteinführungen sowie die neuesten wissenschaftlichen Erkenntnisse stets in Ihrem Posteingang.
- Wenn du dich für eine Auswahl entscheidest, wird die Seite komplett aktualisiert.
- Wird in einem neuen Fenster geöffnet.







